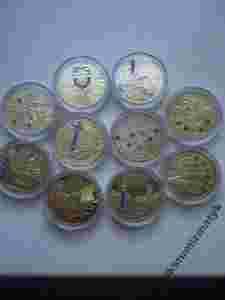

ZESTAW DWOJEK 2010 Z CYRKONIAMI CYRKONIE RARYTAS
Aukcja w czasie sprawdzania była zakończona.
Cena kup teraz: 50 zł
Aktualna cena: 50 zł
Użytkownik wielkinumizmatyk
numer aukcji: 3877299952
Miejscowość Kalisz
Licytowało: 1
Wyświetleń: 30
Koniec: 11-02-2014, 8:37
